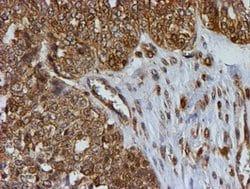
PSMB9 Mouse anti-Human, Clone: OTI1C4, lyophilized, TrueMAB 100 &mu;g;
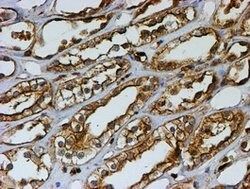
PSMB9 Mouse anti-Human, Clone: OTI1C4, lyophilized, TrueMAB 100 &mu;g;

Learn More
PSMB9 Mouse anti-Human, Clone: OTI1C4, lyophilized, TrueMAB™


Mouse Monoclonal Antibody
Supplier: OriGene CF504348

Description
Reconstitute with PBS (pH 7.3) and recommend to perform another round of desalting process using Product No. 7KMWCO
The proteasome is a multicatalytic proteinase complex with a highly ordered ring-shaped 20S core structure. The core structure is composed of 4 rings of 28 non-identical subunits; 2 rings are composed of 7 alpha subunits and 2 rings are composed of 7 beta subunits. Proteasomes are distributed throughout eukaryotic cells at a high concentration and cleave peptides in an ATP/ubiquitin-dependent process in a non-lysosomal pathway. An essential function of a modified proteasome, the immunoproteasome, is the processing of class I MHC peptides. This gene encodes a member of the proteasome B-type family, also known as the T1B family, that is a 20S core beta subunit. This gene is located in the class II region of the MHC in the immunoproteasome. Proteolytic processing is required to generate a mature subunit.Specifications
| PSMB9 | |
| Monoclonal | |
| Unconjugated | |
| PSMB9 | |
| LMP2, PSMB6i, RING12, beta1i | |
| Mouse | |
| Affinity Chromatography | |
| RUO | |
| 5698 | |
| -20° C, Avoid Freeze/Thaw Cycles | |
| Lyophilized |
| Flow Cytometry, Immunohistochemistry (Paraffin), Western Blot | |
| OTI1C4 | |
| PBS with 8% trehalose and no preservative; pH 7.3 | |
| P28065 | |
| PSMB9 | |
| Human recombit protein fragment corresponding to amino acids 21-219 of human PSMB9 produced in HEK293T cell. | |
| 100 μg | |
| Primary | |
| Human | |
| Antibody | |
| IgG2b |
The Fisher Scientific Encompass Program offers items which are not part of our distribution portfolio. These products typically do not have pictures or detailed descriptions. However, we are committed to improving your shopping experience. Please use the form below to provide feedback related to the content on this product.